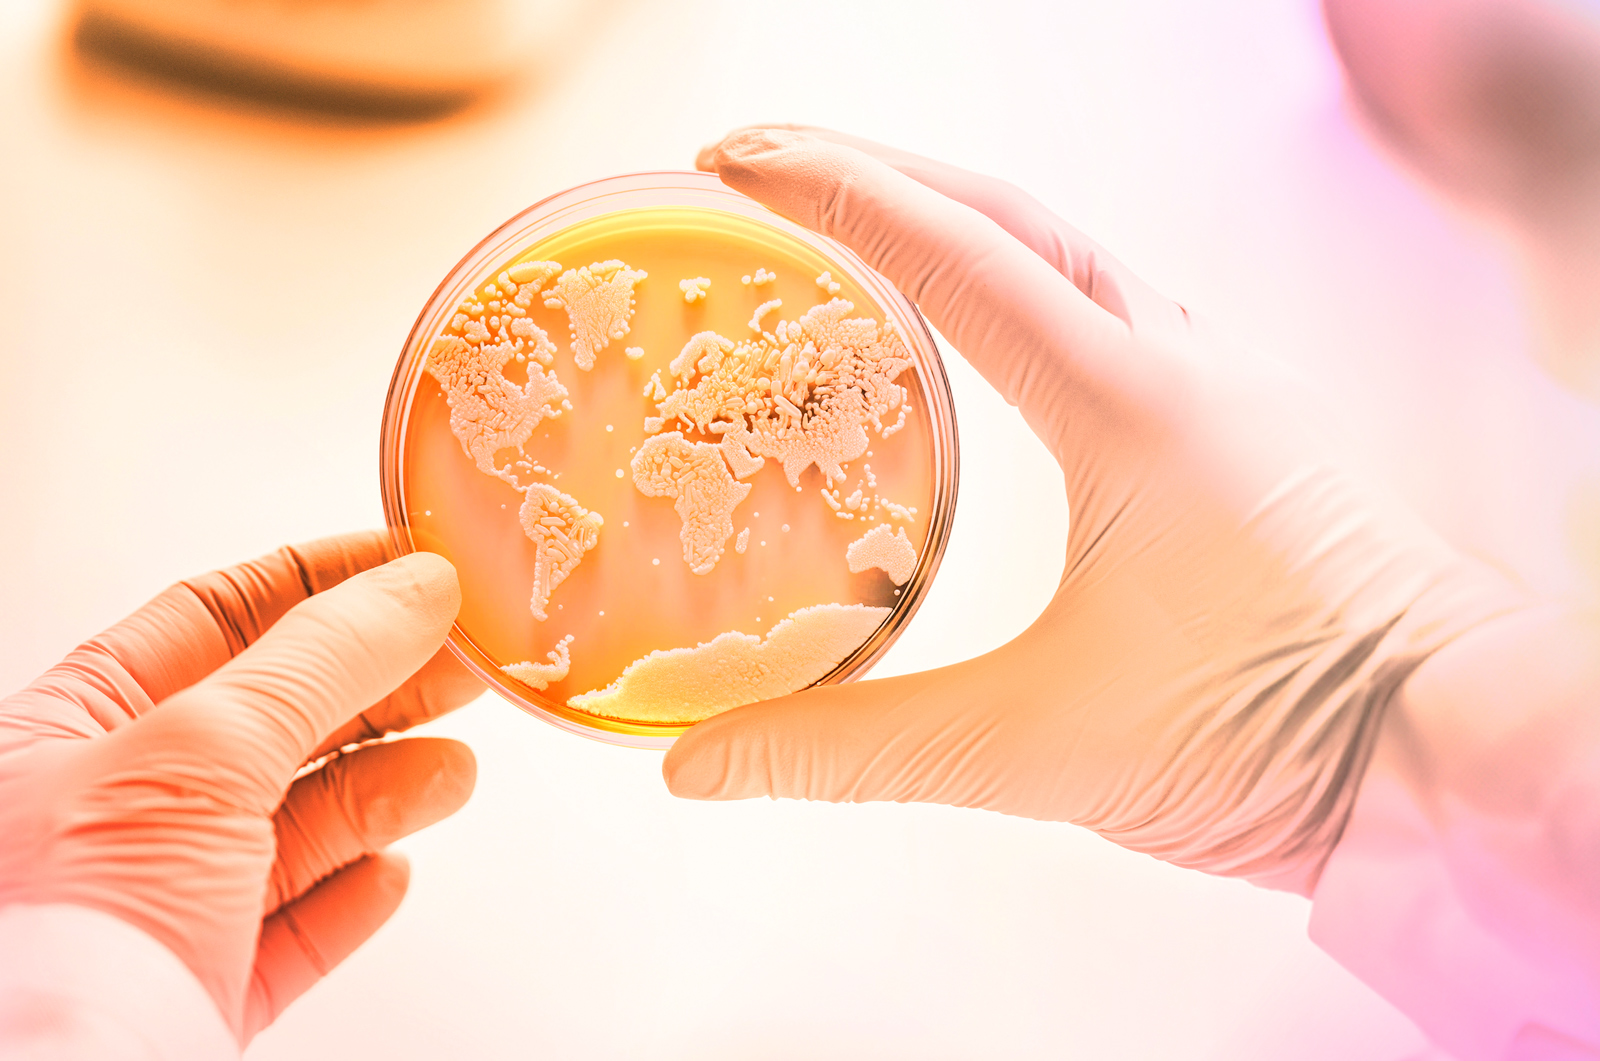

30. September 2025
PlasmidFactory treibt Gen- und Zelltherapie voran
Von Bielefeld in die Welt
Bielefeld gilt nicht als Biotech-Hub. Doch mit außergewöhnlich reinen Plasmiden und Minicircle-DNA lenkt das weltweit tätige und in Bielefeld verwurzelte Unternehmen PlasmidFactory den Fokus auf die Region. Die Produkte kommen in der Gen- und Zelltherapie sowie bei mRNA-Anwendungen für Krebstherapien und Impfstoffen zum Einsatz.
In all diesen Bereichen kommt man an Plasmiden nicht vorbei. Sie sind das Ausgangsmaterial für viele Anwendungen. „Für die Krebstherapie ergeben sich dadurch neue Möglichkeiten“, betonen die Geschäftsführer Dr. Martin Schleef und Dr. Dirk Winnemöller.
2000 gegründet, treibt der Biotechnologiepionier seit 25 Jahren den Fortschritt im Gesundheitswesen voran. „Unser Ziel ist es, visionäre Forschung mit außergewöhnlichen Techniken zu forcieren und den Fortschritt im Gesundheitswesen zu fördern, um klinische Forschungsprogramme unserer Kunden mit außergewöhnlich reinen Plasmid- und Minicircle-DNA voranzubringen“, erklärt Gründer Dr. Martin Schleef. Der Biologe studierte und promovierte an der Universität Bielefeld mit dem Schwerpunkt Genetik und forschte später am Institut Pasteur in Paris. Seit der Gründung fließt in den Laboren von PlasmidFactory wissenschaftliches und technisches Know-how für die kontinuierliche Optimierung des DNA-Produktionsprozesses aus wissenschaftlichen Erfahrungen und fortgesetzten Kooperationen – beispielsweise mit der Universität Bielefeld – ein.
Neue Produktionsanlagen für Minicircle- und Plasmid-DNA in GMP-Qualität

Im Jubiläumsjahr wird das Unternehmen einen hochmodernen ca. 500 qm großen Neubau zur Produktion von Minicircle- und Plasmid-DNA mit einem signifikanten Investitionsvolumen in Betrieb nehmen. „Die Anlage ist weltweit die erste ihrer Art“, freuen sich Martin Schleef und Dirk Winnemöller. Produziert wird nach pharmazeutischen Standards. Bereits 2021 erweiterte PlasmidFactory seine Kapazitäten am Bielefelder Standort: Mit finanzieller Unterstützung des Landes NRW entstand damals ein Produktionsgebäude für Plasmid-DNA als Ausgangsstoff zur Herstellung von Covid-Impfstoffen. „Unsere Produkte sind Vorstufe oder Teil eines Medikaments. Wie wichtig Plasmide sind, haben wir allerdings deutlich durch Corona gespürt, als es darum ging, die Impfstoffproduktion aufrechtzuerhalten“, erklärt Martin Schleef. „Wir waren zur richtigen Zeit an einem Punkt, wo wir mit dem, was wir tun, unterstützen konnten. Heute freuen wir uns, dass wir verschiedenste therapeutische Ansätze unterstützen können, zum Beispiel Minicircle-DNA bei der Herstellung von CAR-T-Zellen, Plasmide als Ausgangsmaterial für Lentiviren (z.B. für CAR-T), für AAV (Gentherapie) oder linearisierte DNA für mRNA-Anwendungen.“
Minicircle-Technologie als Innovationssprung
Der Vorteil der Minicircle-Technologie, für die das Bielefelder Unternehmen die relevanten Patente besitzt: Sie stellen eine neue Form von „Plasmiden“ dar, sind kleiner und wirksamer. „Für die Krebstherapie sind sie besonders interessant, weil die Anwendung zukünftig das bisherige Verfahren, mittels modifizierter Viren vorzugehen, ersetzen kann und dadurch die Sicherheit der Krebstherapie deutlich verbessert“, unterstreichen die beiden Geschäftsführer. Fast ebenso lange, wie Plasmid-Factory existiert, unterstützt das Unternehmen auch im Bereich Krebstherapie in Zusammenarbeit mit Hochschulen, biotechnologischen und Pharma-Partnern.
„Unser Ziel ist es, visionäre Forschung mit außergewöhnlichen Techniken zu forcieren und den Fortschritt im Gesundheitswesen zu fördern, um klinische Forschungsprogramme unserer Kunden mit außergewöhnlich reinen Plasmid- und Minicircle- DNA voranzubringen.“
Dr. Martin Schleef
Mit Minicircle-DNA anstelle von Plasmid-DNA Zellen zu behandeln war bislang unvorstellbar, da die bisherigen Methoden eine zu geringe Wirksamkeit zeigten. „Wir haben uns auf die CAR-T-Zell-Entwicklung fokussiert. Eine mögliche Anwendung ist eine Immuntherapie gegen Krebs. Hierbei machen T-Zellen gezielt Jagd auf Tumorzellen im Patientenkörper und lassen das Immunsystem für sich arbeiten. Dafür werden T-Zellen so ausgerüstet, dass sie Tumore als fremd entlarven und zerstören können. Erste klinische Studien laufen und erzeugen viel Aufmerksamkeit im Markt“, weiß Martin Schleef.
Von der Uni-Ausgründung zum Global Player

PlasmidFactory entstand als Ausgründung der Universität Bielefeld und wuchs zunächst im Technologiezentrum. Von Anfang an treibt die Balance zwischen Forschung und Produktion das Unternehmen an und um. „Doch in erster Linie sehen wir uns als Forschende; als Wissen-schaftler*innen, die ein Unternehmen betreiben“, formuliert Martin Schleef das Selbstverständnis. Die ersten vier Jahre nach der Gründung brachten einige Herausforderungen mit sich: von der Finanzierung bis hin zu den Gerätschaften, die man in der Biotechnologie benötigt. „Wir haben von unseren guten Verbindungen zur Uni Bielefeld profitiert und konnten uns dort ein Labor mieten“, erinnert sich Martin Schleef im Jubiläumsjahr an die Anfänge. In den ersten 20 Jahren wuchs das Unternehmen langsam, aber stetig um einen Mitarbeitenden pro Jahr. „Während der Bankenkrise 2011 haben wir eine Art Stagnation erlebt“, wirft er einen Blick zurück. Inzwischen beschäftigt das biopharmazeutische Unternehmen 52 Mitarbeitende, da die Zahl der Mitarbeitenden im Zuge der Erweiterung um zwei Produktionsgebäude deutlich schneller steigt, und ist noch heute mit Kund*innen aus den ersten Jahren eng verbunden. „Darauf sind wir sehr stolz. Diese lange Kunden- und Kooperationshistorie auch mit Wissenschaftler*innen ist ganz typisch für uns.“
Strategische Partnerschaften und Forschung
Neben eigener Forschung und Entwicklung mit Fokus auf die Gen- und Zelltherapie arbeitet PlasmidFactory eng mit industriellen und akademischen Partner*innen zusammen. Ganz nach dem Motto: Gemeinsam lassen sich Herausforderungen einfacher lösen. „Der Weg eines innovativen Produkts von der Entwicklung bis zur Marktreife ist lang und kostenintensiv. Partnerschaften erleichtern diesen Prozess“, erklärt Dirk Winnemöller. Forschungskooperationen – auch mit Blick auf Technologietransfer und Lizenzen – bestehen z.B. mit der Uni Bielefeld und dem deutschen Krebsforschungszentrum. Verbindlich Verbindungen zu schaffen ist dem Unternehmen wichtig. Auch mit Blick auf das Thema Fachkräftesicherung. „Durch Vorlesungen an der Uni Bielefeld zum Thema ‚Qualitätsmanagement in der Biotechnologie‘ am Beispiel von Plasmiden geben wir der Universität etwas zurück, machen auf uns aufmerksam und gewinnen Werkstudierende. Auch einen Großteil unserer Mitarbeitenden rekrutieren wir aus den Hochschulen der Region“, so Martin Schleef.
Kunden weltweit

Als ein führender Anbieter von Plasmid- und Minicircle-DNA beliefert PlasmidFactory Kunden aus den Bereichen Gen- und Zelltherapie, CAR-T-Zellentwicklung und genetische Impfung mit mRNA weltweit. „Der sehr hohe Reinheitsgrad unserer Produkte und die besonderen Eigenschaften der Minicircle-DNA wirken sich direkt auf die Prozesse bei der Herstellung von Medikamenten aus, können zum Beispiel für eine Produktionssteigerung bei den Unternehmen sorgen und sich dadurch auch bei höheren Kosten pro Gramm DNA wirtschaftlich sehr positiv auswirken“, macht Dirk Winnemöller deutlich. Die Kundenstruktur selbst ist vielfältig, reicht von der kleinen Uni-Forschenden-Gruppe bis hin zum Top-Ten-Pharmaunternehmen mit 100.000 Mitarbeitenden. Ein Großteil der Kunden hat seinen Sitz in Deutschland und Europa. „Wir agieren aber schon seit vielen Jahren weltweit und arbeiten kontinuierlich am Ausbau unserer Internationalisierung. Deshalb bauen wir jetzt Strukturen auf, um stärker auch auf dem US-Markt zu expandieren“, betont Martin Schleef, der die Entwicklung der PlasmidFactory GmbH vorausschauend wie zukunftsgerichtet vorangetrieben hat.
Am 1. September übergab er den Staffelstab an Dr. Dirk Winnemöller, der im Bereich Biotech und klinische Forschung seit 20 Jahren zuhause ist und über viele Jahre Erfahrung in der Zell- und Gentherapie verfügt. Den gebürtigen Rheinländer hat Martin Schleef sechs Monate vor dem Stichtag ins Unternehmen geholt. „Eine gute Einarbeitung und Übergabe finde ich entscheidend. Sie macht es für alle Seiten einfacher“, so Martin Schleef, der das Unternehmen weiterhin als Teil-Eigentümer beratend begleiten wird und sich auf die neue Aufgabe freut.
Werte und Verlässlichkeit als Erfolgsfaktor
Verlässlich, bodenständig und transparent zu arbeiten ist dem Team der PlasmidFactory seit jeher wichtig. „An unseren Werten und der Einstellung hat sich bis heute nichts verändert. Denn: Unsere Kund*innen müssen sich auf uns verlassen können“, betont Martin Schleef. „Viele von ihnen schätzen es sehr, dass sie in Deutschland Plasmide kaufen können. Wir stehen für extreme Kundenzufriedenheit, Aufrichtigkeit, Qualität und Innovation.“ „Unsere Innovationskraft nehmen sie als entscheidendes Feature wahr und finden bei uns maßgeschneiderte Lösungen“, ergänzt Dirk Winnemöller.



